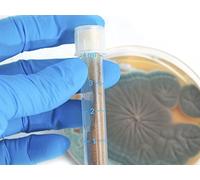
1928-The Discovery of Penicillin

£3.37
Amazon-marketplace.co.uk
Delivery from £1.99
![DUKE ELLINGTON - 1928-1962 THE ESSENTIAL WORKS [VINYL]](https://cdn.pricehunter.co.uk/offer/en/duke-ellington-1928-1962-the-essential-works-vinyl-200t180d47a2c19e1799a060dd108a9e113c2800b892776.jpg)
£36.02
Amazon-marketplace.co.uk
Delivery from £1.26

£10.73
Amazon-marketplace.co.uk
Delivery from £2.49

£95.71
Amazon-marketplace.co.uk
Delivery from £4.99

£11.08
amazon.co.uk
Delivery from £2.99

£13.23
amazon.co.uk
Delivery from £2.99

£26.08
Amazon-marketplace.co.uk
Delivery from £2.80

£8.13
Amazon-marketplace.co.uk
Delivery from £10.67
![Our Century 1918 - 1928 - The Years Of Jazz [DVD]](https://cdn.pricehunter.co.uk/offer/en/our-century-1918-1928-the-years-of-jazz-dvd-200t180c946507232a8748a6c2e995b21820b17b32c23d4.jpg)
£8.49
Amazon-marketplace.co.uk
Delivery from £1.26

Pablo Casals The Early Recordings 1925-1928 (CD) (US IMPORT)
£15.25
ebay.co.uk
Free Delivery
![La Última Orden BD 1928 The Last Command [Blu-ray]](https://cdn.pricehunter.co.uk/offer/en/la-ultima-orden-bd-1928-the-last-command-blu-ray-200t1802a99eb3832d1d95bf9f9de8599316287c08e26e1.jpg)
£9.12
Amazon-marketplace.co.uk
Delivery from £8.40
![The Passion Of Joan Of Arc Blu-Ray + DVD [2017]](https://cdn.pricehunter.co.uk/offer/en/the-passion-of-joan-of-arc-masters-of-cinema-blu-ray-200t180156774d2f7686d06e41da3fbaee4bfafafec2a07.jpg)
£13.91
Amazon-marketplace.co.uk
Delivery from £2.80

THE SINGING FOOL 1928 DVD Region 0 AL JOLSON BETTY BRONSON JOSEPHINE DUNN LLOYD BACON
£9.95
Amazon-marketplace.co.uk
Delivery from £7.30

The NewLine CVN1928 Joint kit, drive shaft
£103.99
autodoc.co.uk
Delivery from £8.45
![Winston Churchill: The Wilderness Years - Volume 1, 1928-32 [VHS]](https://cdn.pricehunter.co.uk/offer/en/winston-churchill-the-wilderness-years-volume-1-1928-32-vhs-200t1805163d4a42ff6a15f9bae281124c6c8ccfeb82b9f.jpg)
Winston Churchill: The Wilderness Years - Volume 1, 1928-32 [VHS]
£13.96
Amazon-marketplace.co.uk
Delivery from £2.80

1928-The Discovery of Penicillin
£1.89
Amazon-marketplace.co.uk
Delivery from £3.99
![Winston Churchill: The Wilderness Years, 1928-39 (Box Set) [DVD]](https://cdn.pricehunter.co.uk/offer/en/winston-churchill-the-wilderness-years-1928-39-box-set-dvd-200t180ef44fbc3ad3eaa121a9421590ac1b879da2d2b87.jpg)
Winston Churchill: The Wilderness Years, 1928-39 (Box Set) [DVD]
£84.95
Amazon-marketplace.co.uk
Delivery from £8.95
![Winston Churchill: The Wilderness Years - Volume 1, 1928-32 [DVD] by Robert Hardy](https://cdn.pricehunter.co.uk/offer/en/winston-churchill-the-wilderness-years-volume-1-1928-32-dvd-by-robert-hardy-200t180e7dc3801c877863f994fba32a75db53d2cfb317c.jpg)
Winston Churchill: The Wilderness Years - Volume 1, 1928-32 [DVD] by Robert Hardy
£19.99
Amazon-marketplace.co.uk
Delivery from £1.26
![El Fotografo BD 1928 The Cameraman [Blu-ray]](https://cdn.pricehunter.co.uk/offer/en/el-fotografo-bd-1928-the-cameraman-blu-ray-200t18099da3694617f658f71c63a76a8896803b84e2431.jpg)
£15.99
Amazon-marketplace.co.uk
Delivery from £3.99

The Farmer's Wife 1928
£15.74
Amazon-marketplace.co.uk
Delivery from £7.74
1928-The Discovery of Penicillin
£2.49
Amazon-marketplace.co.uk
Delivery from £3.99

£71.21
Amazon-marketplace.co.uk
Delivery from £5.00

£33.98
Amazon-marketplace.co.uk
Delivery from £2.80

£44.08
Amazon-marketplace.co.uk
Free Delivery

£47.62
Amazon-marketplace.co.uk
Free Delivery

£106.36
Amazon-marketplace.co.uk
Delivery from £5.00

£34.95
amazon.co.uk
Free Delivery

£19.94
Amazon-marketplace.co.uk
Delivery from £7.74

£27.05
Amazon-marketplace.co.uk
Free Delivery

£16.35
Amazon-marketplace.co.uk
Delivery from £25.28

£70.83
amazon.co.uk
Free Delivery

£11.77
amazon.co.uk
Free Delivery

£100.57
amazon.co.uk
Free Delivery

£18.91
Amazon-marketplace.co.uk
Delivery from £4.50

£12.98
Amazon-marketplace.co.uk
Delivery from £2.99

£14.41
Amazon-marketplace.co.uk
Delivery from £10.13

£3.15
Amazon-marketplace.co.uk
Delivery from £2.80

£48.41
Amazon-marketplace.co.uk
Free Delivery

£12.89
Amazon-marketplace.co.uk
Delivery from £1.26

£72.62
Amazon-marketplace.co.uk
Free Delivery
- 1
- 2
- 3
- 4
- 5
- next page
🤖 Ask ChatGPT
🛍️ What are the most important purchase criteria?
💰 Tell me the best deals!
📋 Create a short summary!
Informations about "the 1928 new"
Check 3,392 offers for your search.
Pricehunter was able to locate products in 28 categories, ranging from £0.99 to £16,950.00.
About "the 1928 new"
- In total, Pricehunter was able to locate 15 proposals, from providers such as dorothyperkins.com, Jurawatches.co.uk, Zavvi.com (UK) and farfetch.com (UK).
- If you would prefer an item from a particular brands, you can find 14 mail order companies for this product. If you have not yet made a decision, you can also filter your favourite producers and choose between 14 manufacturers.
- The most offers (133) were found in the price range from £19.00 to £19.99.
- Customers who looked for this item also found interesting.
- With our extensive colour palette you can select your favourite colour for your article. Of the available 0 coloration is the most frequently chosen.
Don't forget your voucher code:
Report Illegal Concerns
You are about to report a violation based on the EU Digital Services Act (DSA).